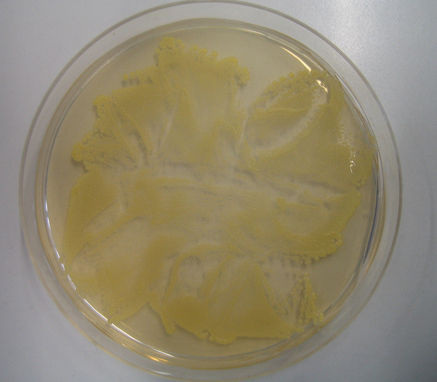
Staphylococcus aureus auf Agar (© Wikipedia)

In ASU 4/2013 veröffentlichte Frau Dr. Monika Stichert einen Artikel über die Vorgehensweise bei MRSA-positiven Mitarbeitern. Dabei legte sie verständlicherweise den Schwerpunkt auf das Personal in Krankenhäusern oder Altersheimen. Allerdings ist das Vorgehen in den EU-Ländern sehr unterschiedlich und weicht, wie beispielsweise auch die Weiterbildungsregularien, stark voneinander ab.
Dieser Artikel schildert die Vorgangsweise in den Niederlanden. Da der Autor früher selbst beruflich bei einem ARBO-Dienst (allgemeine Bezeichnung für arbeitsmedizinische Dienste in Holland) tätig war, sind ihm die aktuellen Richtlinien geläufig (s. Literatur). Allerdings muss darauf hingewiesen werden, dass es sich um allgemeine Richtlinien handelt. Jede Klinik, jedes Seniorenheim etc. kennt eigene Regelungen. Davon abgesehen, installiert jede Einrichtung ihre MRSA-Kommission. In einem Krankenhaus sind dies im Allgemeinen ein Mikrobiologe, die Krankenhaushygiene, der Klinikapotheker, der Vorstand einer Abteilung und der behandelnde Facharzt. Je nach Gegebenheiten können weitere Spezialisten mit einbezogen werden (z. B. der Arbeitsmediziner, wenn es um das Personal geht).
Allgemeines zur MRSA-Prävention in den Niederlanden
In den Niederlanden wird schon seit den 80er Jahren eine konsequente Präventionspolitik betrieben. Die Ergebnisse geben den Niederlanden recht. Denn in holländischen Krankenhäusern stellt MRSA – wie auch in den skandinavischen Ländern – nur ein geringes Problem da. Diese Erfolge konnten nur durch die konsequente „Search and Destroy“-Strategie erzielt werden.
Im Nachbarland Belgien stellt MRSA ein viel größeres Problem dar. In den holländi-schen Richtlinien wird festgehalten, dass ausländische Kliniken als Risiko angesehen werden. Dies bedeutet, dass z. B. Patienten, die in einem deutschen Krankenhaus einen Tag lang aufgenommen waren, vor dem Rücktransport nach Holland einen negativen MRSA-Abstrich vorweisen müssen. Bei positivem Testresultat kommt ein Patient in Quarantäne. Von einer Epidemie wird gesprochen, wenn zwei oder mehr Patienten mit derselben MRSA-Variante infiziert oder kolonisiert sind. Dann wird die MRSA-Kommission informiert. In den Niederlanden ist zudem eine Meldepflicht vorgesehen.
Vier Risikokategorien bezüglich der Mitarbeiter
-
Kategorie 1:
- Mitarbeiter, bei denen MRSA-Träger-schaft bewiesen ist.
-
Kategorie 2:
- Mitarbeiter, die ungeschützten Kontakt mit MRSA-Trägern hatten.
- Mitarbeiter, die innerhalb von zwei Monaten in einer ausländischen Klinik aufgenommen waren, z. B. mit Intubationen, Katheter, Drainage etc. oder Hautläsionen (Abszesse, Fu-runkel etc.).
-
Kategorie 3:
- Mitarbeiter, die geschützt mit einem MRSA-Träger in Kontakt gekommen sind.
- Mitarbeiter, die innerhalb der letzten zwei Monate einen ganzen Tag ( 24 Stunden) an einem ausländi-schen Klinikum oder Pflegeheim gearbeitet haben.
- Mitarbeiter, die regelmäßig in aus-ländischen Krankenhäusern tätig oder regelmäßig an Überführungen nach Holland beteiligt sind.
- Mitarbeiter, die Träger waren und bei einem Kontrollabstrich nach einem Jahr negativ sind.
-
Kategorie 4:
- Mitarbeiter, die vor mehr als einem Jahr erfolgreich behandelt wurden (Kontrollabstrich ein Jahr nach Infektion).
- Mitarbeiter, bei denen nach dem letzten geschützten Kontakt die Proben (innerhalb von drei Wochen) negativ sind.
Maßnahmen in Hinblick auf das Personal
In den Niederlanden unterscheidet man bezüglich der bakteriologischen MRSA-Untersuchungen zwei Verfahren:
- 1. Abstriche zur Inventarisierung und
- 2. zweitens Kontrollabstriche.
Ersteres wird abgenommen bei
- Mitarbeitern, die einen MRSA-positiven Patienten versorgen,
- Mitarbeitern, die im Ausland tätig waren und
- Beschäftigten, die unerwartet Kontakt mit einem MRSA-positiven Patienten hatten.
Dabei werden Proben im Bereich des Nasenvorhofs, des Rachens und eventueller Hautläsionen (beispielsweise ein Handekzem) genommen. Hierbei spielt es eine Rolle, wie lange der MRSA-positive Patient auf der Abteilung anwesend war. Bei einem kurzen Aufenthalt werden so genannte Ring-untersuchungen durchgeführt, bei denen jenes Personal getestet wird, das direkten Kontakt zu dem Träger hatte (z. B. Physiotherapeuten oder Pflegepersonal). War der Patient länger in der Abteilung, kommt es zu einer Kontrolle bei allen Mitarbeitern dieser Abteilung.
Vorgehensweise bei Mitarbeitern der Kategorie 1
-
MRSA-positive Mitarbeiter mit Hautläsionen:
- Personal der Kategorie 1 mit Hautläsionen darf keine Tätigkeiten in Abteilungen ausführen, wo Patienten anwesend sind. Am 1. Tag wird ein Abstrich vom Nasenvorhof, dem Rachen, dem Perineum und Hautläsionen vorgenommen. Ferner wird nach der Probenabnahme eine Behandlung nach der Swab-Richtlinie eingeleitet ( http://www.swab.nl ).
- Am 10., 15. und 20. Tag werden Kon-trollen abgenommen. Der Arbeitnehmer darf den Arbeitsplatz erst dann wieder betreten, wenn alle drei Kontrollen negativ waren.
-
MRSA positive Mitarbeiter ohne Hautläsionen:
- In diesem Fall dürfen Mitarbeiter zwei Tage lang keine Arbeiten in Bereichen verrichten, wo Patienten anwesend sind. Mit der Behandlung wird ebenso direkt begonnen. Am ersten Tag werden wiederum vor der Behandlung Proben vom Nasenvorhof, Rachen und dem Perineum abgenommen.
- Sind am 5. Tag die Resultate der ers-ten Probe positiv, wird ein Arbeitsverbot ausgesprochen. Danach werden Kontrollabstriche am 10., 15. und 20. Tag abgenommen. Der Mitarbeiter darf erst wieder beginnen, wenn alle drei Kontrollen negativ ausfallen. Ist die Probe am 5. Tag negativ, darf der Arbeitnehmer wieder arbeiten. Er muss sich jedoch ebenso den restlichen Kontrollen unterziehen.
In der Richtlinie wird ferner angeraten, bei Personen der Kategorie 1 standardmäßig drei Monate nach den Kontrollabstrichen noch eine Probe zu nehmen. Bei Personen mit Hautläsionen etc. werden sogar Langzeitkontrollen angeraten. Allerdings wird darauf nicht näher in den Richtlinien eingegangen und der Beschluss dürfte dann Teil der MRSA-Kommission einer Einrichtung sein. Sollte die Standardbehandlung mit einer Mupirocinsalbe keinen Erfolg aufweisen, wird ebenso angeraten, den Patienten/Mitarbeiter zu einem Spezialisten bezüglich MRSA zu verweisen.
Vorgehensweise bei Mitarbeitern der Kategorie 2
- Ein Mitarbeiter der Kategorie 2, der in einem ausländischen Klinikum war, darf in den Niederlanden nicht direkt wieder seine Tätigkeit aufnehmen. Erst muss ein Abstrich zur Inventarisierung zeigen, dass der Arbeitnehmer MRSA-frei ist.
- Bei den Arbeitnehmern, die einen ungeschützten Kontakt zu MRSA-positiven Patienten hatten, werden ebenfalls Proben zur Inventarisierung abgenommen. Wenn diese positiv ausfallen, folgt ein Arbeitsverbot und im Weiteren wird wie bei Mitarbeitern der Kategorie 1 verfahren. Personal, bei dem sich aus anderen Gründen zeigt, dass eine Kolonisation stattgefunden hat, sollte ebenfalls wie Mitarbeiter der Kategorie 1 behandelt werden.
Vorgehensweise bei Mitarbeitern der Kategorie 3
Ein Mitarbeiter der Kategorie 3 darf seine Arbeiten wie gewöhnlich verrichten. Es müs-sen jedoch auch Proben abgenommen werden. Sollte der Mitarbeiter regelmäßig im Ausland tätig sein, werden sogar ständige Kontrollen erwartet. Im Allgemeinen wird zuvor abgesprochen, wie häufig diese durchführt werden sollten. Dabei gilt es, die Arbeitsumgebung und das Risiko auf eine Exposition zu berücksichtigen. Jene Mitarbeiter dürfen aber ganz normal ihren Job ausüben.
Vorgehensweise bei Mitarbeitern der Kategorie 4
Bei Mitarbeitern der Kategorie 4 sind keine speziellen Maßnahmen vorgesehen.
Was passiert, wenn die Therapie bei einem Träger nicht anschlägt?
Eine persistierende MRSA-Besiedelung kann für den Arbeitnehmer im extremsten Fall die Kündigung bedeuten. In den Niederlanden wurde vor rund zehn Jahren ein Fall beschrieben, wo eine Krankenschwester fast 15 Monate nicht arbeiten durfte, weil sie MRSA-positiv war. Die betroffene Person hat sich damals sogar einer Tonsillektomie unterzogen, um ihren Beruf weiter ausüben zu können. Der Lehrvertrag ihres Bruders (Krankenpfleger), den sie angesteckt hatte, wurde noch in der Probezeit aufgelöst.
Aufgrund dieses Falls wurde in einem anderen Artikel die damalige Rechtslage besprochen. Dabei wurde festgehalten, dass der Arbeitgeber für den möglichen Schaden (Lohnausfall, Karriere etc.) haften muss, wenn er nicht für die notwendige Prävention (Befolgen der Richtlinien, Protokolle etc.) gesorgt hat. Die Beweislast liegt dabei beim Arbeitgeber. Hätte die Betroffene ihren Beruf nicht mehr ausüben können und später in anderen Berufen Einkommensverluste erlitten, müsste der Lohnunterschied ebenso von Arbeitgeber beglichen werden.
Ferner muss der Arbeitgeber zu 100 % für die Kosten während des Krankenstandes aufkommen. Die derzeitige niederländische Rechtslage schreibt vor, dass die ersten zwei Jahre des Gehalts durch den Arbeitgeber zu zahlen sind. Außerdem ist der niederländische Arbeitgeber zur Wiedereingliederung verpflichtet. Das bedeutet, dass in diesem Fall eine passende Arbeit im oder außerhalb des Krankenhauses hätte gesucht werden müssen.
Schlusswort
Dieser Artikel stellt eine allgemeine Wiedergabe der Richtlinien in Krankenhäusern und Pflegeheimen der Niederlande dar. Grundsätzlich wird in allen Häusern ähnlich verfahren, es gibt jedoch auch eigene Richtlinien für die Hauspflege etc. Alles genau zu beschreiben, würde den Rahmen dieses Beitrags sprengen. Ob die holländischen Maßnahmen wirklich notwendig sind, wird ebenso offen gelassen. Ein Blick über die Grenzen lohnt aber allemal, denn die dortige Vorgehenssweise zeigt gute Erfolge.
Schlussendlich stellt sich m. E. die Frage, wie sich künftig arbeitsmedizinische Maßnahmen innerhalb der EU-Länder überhaupt angleichen lassen, da die bestehenden Unterschiede doch enorm sind.
Literatur
Niederländische WIP-Richtlinie: MRSA für ein Krankenhaus und MRSA für Pflegeheime unter http://www.wip.nl/UK/
MRSA rivisited, Nursing; Mei 2005: http://mrsa-net.nl/files/nl/file-eg-ant-72-0-verhaalvpkthuisdoorMRSA.pdf
Vraag over MRSA als Beroepsaandoening – Welke gevolgen heeft MRSA. Nursing; Februari 2004: http://mrsa-net.nl/files/nl/file-bron-ant-10034-0-beroepsaandoening.pdf
Weitere Infos
MDK-Forum: Arbeitsunfähigkeit im europäischen Vergleich
http://www.mdk.de/media/pdf/MDK_Forum_2010-4.pdf
Krankenstand – Hilfe von Doc Holiday: Die Zeit; Oktober 2011
Autor
Dr. med. Arie M. Rijkenberg
Facharzt für Arbeitsmedizin
Arbeitsmedizinische Abteilung des Sozialdienstes von Antwerpen Luitenant Lippenslaan 59
2140 Borgerhout/Antwerpen
ZuM Autor
Arie Rijkenberg studierte in Innsbruck und Groningen Medizin. Ferner absolvierte er einen Master of Occupational Medicine in Flandern. Nach einer Tätigkeit in einer Tiroler Lehrpraxis für Allgemeinmedizin emigrierte er zunächst in die Niederlande, wo er auch für die TNO tätig war. Derzeit arbeitet er beim arbeitsmedizinischen Dienst des Sozialdienstes von Antwerpen, wo er unter anderem ein Krankenhaus und mehrere Pflegeheime betreut.